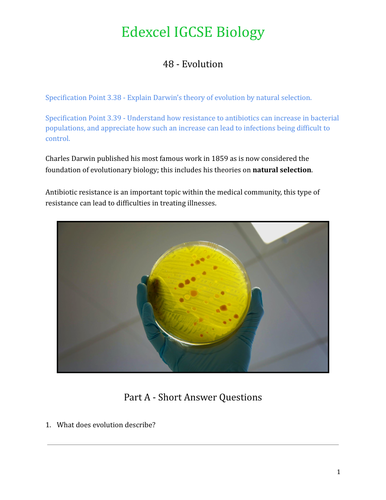
pdf, 1.87 MB

This set is designed to be bought as part of the Complete Edexcel IGCSE Science Bundle
The complete Edexcel IGCSE Biology course from start to finish. Huge bundle of resources with every topic covered.
Complete set of companion PDF worksheets for Edexcel IGCSE Biology (4BI0) Chapters 1 - 7. This pack contains 62 worksheets, including:
1 - Characteristics of Living Organisms
2 - Variety of Living Organisms
3 - Organisation and Cell Structure
4 - Cell Differentiation
5 - Biological Molecules
6 - Food Tests
7 - Enzymes
8 - Enzymes and pH
9 - Movement Across Membranes
10 - Nutrition in Plants
11 - The Leaf
12 - Investigating Photosynthesis
13 - Human Nutrition
14 - The Digestive System
15 - Digestion and Absorption
16 - Energy in Food
17 - Respiration
18 - Gas Exchange in Plants
19 - Ventilation
20 - The Alveoli and Lung Disease
21 - Transport Mechanisms
22 - Transpiration
23 - The Blood
24 - Vaccination
25 - The Heart
26 - The Circulatory System
27 - Excretion
28 - The Kidneys
29 - Coordination
30 - Coordination in Plants
31 - Coordnation in Animals
32 - Reflexes and the Eye
33 - Controlling Body Temperature
34 - Hormones
35 - More Hormones
36 - Reproduction
37 - Reproduction in Plants
38 - Human Reproductive Systems and the Menstrual Cycle
39 - FSH and LH
40 - Pregnancy and Puberty
41 - DNA, Genes and Chromosomes
42 - Nucleic Acids
43 - Inheritance and Codominance
44 - Genetic Diagrams
45 - Cell Division
46 - Variation in a Species
47 - Mutations
48 - Evolution
49 - Ecosystems
50 - Biodiversity
51 - Biotic and Abiotic Factors
52 - Feeding Relationships
53 - The Carbon Cycle
54 - The Nitrogen Cycle
55 - Pollution and Global Warming
56 - Deforestation
57 - Crop Production
58 - Microorganisms for Food
59 - Fish Farming
60 - Selective Breeding
61 - Genetic Modification
62 - Cloning
Get this resource as part of a bundle and save up to 45%
A bundle is a package of resources grouped together to teach a particular topic, or a series of lessons, in one place.
Edexcel IGCSE Science Lessons - Three Complete Courses (Presentations, Worksheets and Mocks)
The complete **Edexcel IGCSE Science Course**. Includes **Biology, Chemistry and Physics** Over **2000 slides and companion PDF worksheets! Huge bundle of resources** with **every topic covered**. **Unbeatable value. The definitive collection.** **Now including a full set of mock exams:** **Includes:** Complete set of concise, modern presentations and companion worksheets for Edexcel IGCSE Biology (4BI0) Chapters 1 - 7. Contains colour coded specification points with **handmade vector graphics**. **62** presentations and worksheets included: 1 - Characteristics of Living Organisms 2 - Variety of Living Organisms 3 - Organisation and Cell Structure 4 - Cell Differentiation 5 - Biological Molecules 6 - Food Tests 7 - Enzymes 8 - Enzymes and pH 9 - Movement Across Membranes 10 - Nutrition in Plants 11 - The Leaf 12 - Investigating Photosynthesis 13 - Human Nutrition 14 - The Digestive System 15 - Digestion and Absorption 16 - Energy in Food 17 - Respiration 18 - Gas Exchange in Plants 19 - Ventilation 20 - The Alveoli and Lung Disease 21 - Transport Mechanisms 22 - Transpiration 23 - The Blood 24 - Vaccination 25 - The Heart 26 - The Circulatory System 27 - Excretion 28 - The Kidneys 29 - Coordination 30 - Coordination in Plants 31 - Coordnation in Animals 32 - Reflexes and the Eye 33 - Controlling Body Temperature 34 - Hormones 35 - More Hormones 36 - Reproduction 37 - Reproduction in Plants 38 - Human Reproductive Systems and the Menstrual Cycle 39 - FSH and LH 40 - Pregnancy and Puberty 41 - DNA, Genes and Chromosomes 42 - Nucleic Acids 43 - Inheritance and Codominance 44 - Genetic Diagrams 45 - Cell Division 46 - Variation in a Species 47 - Mutations 48 - Evolution 49 - Ecosystems 50 - Biodiversity 51 - Biotic and Abiotic Factors 52 - Feeding Relationships 53 - The Carbon Cycle 54 - The Nitrogen Cycle 55 - Pollution and Global Warming 56 - Deforestation 57 - Crop Production 58 - Microorganisms for Food 59 - Fish Farming 60 - Selective Breeding 61 - Genetic Modification 62 - Cloning Complete set of concise, modern presentations and companion worksheets for **Edexcel IGCSE Chemistry** (4CH1) **Chapters 1 - 7** Contains colour coded specification points with **handmade vector graphics**. **38** presentations and worksheets included: 1 - States of Matter 2 - Solutions and Solubility 3 - Calculating Solubility 4 - Elements, Compounds and Mixtures 5 - Methods of Separation 6 - Paper Chromatography 7 - Atoms and Molecules 8 - The Periodic Table 9 - Formulae and Calculations 10 - Formulae and Calculations Part 2 11 - Concentration and Volumes 12 - Ionic Bonding 13 - Covalent Bonding 14 - Metallic Bonding 15 - Electrolysis 16 - Group 1 Elements 17 - Group 7 Elements 18 - Atmospheric Gases 19 - Metals and the Reactivity Series 20 - The Uses of Metals 21 - Acids and Alkalis 22 - Titrations 23 - Acids, Bases and Salts 24 - Making Salts 25 - Chemical Tests 26 - Energetics 27 - Bond Energies 28 - Rates of Reaction 29 - Reversible Reactions 30 - Dynamic Equilibria 31 - Organic Compounds 32 - Crude Oil 33 - Burning Hydrocarbons 34 - Alkanes and Alkenes 35 - Organic Compounds Part 2 36 - Esters 37 - Addition Polymers 38 - Condensation Polymers Complete set of concise, modern presentations and companion worksheets for **Edexcel IGCSE Physics** (4PH1) **Chapters 1 - 8** Contains colour coded specification points with **handmade vector graphics**. **33** presentations and worksheets included: 1 - Distance and Speed 2 - Acceleration 3 - Forces 4 - Balanced and Unbalanced Forces 5 - Gravity, Weight and Drag 6 - Hooke's Law 7 - Momentum 8 - Forces and Moments 9 - Mains Electricity 10 - Power, Current and Voltage 11 - Circuits Part 1 12 - Circuits Part 2 13 - Static Electricity 14 - Waves 15 - Electromagnetic Waves 16 - Reflection and Refraction 17 - Sound Waves 18 - Energy 19 - Thermal Energy 20 - Work and Power 21 - Sources of Energy 22 - Density and Pressure 23 - Changes of State 24 - Ideal Gases 25 - Magnetism 26 - Electromagnets Part 1 27 - Electromagnets Part 2 28 - Radioactivity Part 1 29 - Radioactivity Part 2 30 - Fission and Fusion 31 - The Universe 32 - The Evolution of Stars 33 - Cosmology
Edexcel IGCSE Science Worksheets - Three Complete Courses
The complete **Edexcel IGCSE Science Course**. Includes **Biology, Chemistry and Physics**. **139 PDF worksheets, Huge bundle of resources** with **every topic covered**. **Unbeatable value. The definitive collection.** Complete set of companion PDF worksheets for **Edexcel IGCSE Biology** (4BI0) **Chapters 1 - 7**. This pack contains **62** worksheets, including: 1 - Characteristics of Living Organisms 2 - Variety of Living Organisms 3 - Organisation and Cell Structure 4 - Cell Differentiation 5 - Biological Molecules 6 - Food Tests 7 - Enzymes 8 - Enzymes and pH 9 - Movement Across Membranes 10 - Nutrition in Plants 11 - The Leaf 12 - Investigating Photosynthesis 13 - Human Nutrition 14 - The Digestive System 15 - Digestion and Absorption 16 - Energy in Food 17 - Respiration 18 - Gas Exchange in Plants 19 - Ventilation 20 - The Alveoli and Lung Disease 21 - Transport Mechanisms 22 - Transpiration 23 - The Blood 24 - Vaccination 25 - The Heart 26 - The Circulatory System 27 - Excretion 28 - The Kidneys 29 - Coordination 30 - Coordination in Plants 31 - Coordnation in Animals 32 - Reflexes and the Eye 33 - Controlling Body Temperature 34 - Hormones 35 - More Hormones 36 - Reproduction 37 - Reproduction in Plants 38 - Human Reproductive Systems and the Menstrual Cycle 39 - FSH and LH 40 - Pregnancy and Puberty 41 - DNA, Genes and Chromosomes 42 - Nucleic Acids 43 - Inheritance and Codominance 44 - Genetic Diagrams 45 - Cell Division 46 - Variation in a Species 47 - Mutations 48 - Evolution 49 - Ecosystems 50 - Biodiversity 51 - Biotic and Abiotic Factors 52 - Feeding Relationships 53 - The Carbon Cycle 54 - The Nitrogen Cycle 55 - Pollution and Global Warming 56 - Deforestation 57 - Crop Production 58 - Microorganisms for Food 59 - Fish Farming 60 - Selective Breeding 61 - Genetic Modification 62 - Cloning Complete set of companion PDF worksheets for **Edexcel IGCSE Chemistry** (4CH1) **Chapters 1 - 7**. This pack contains **38** worksheets, including: 1 - States of Matter 2 - Solutions and Solubility 3 - Calculating Solubility 4 - Elements, Compounds and Mixture 5 - Methods of Separation 6 - Paper Chromatography 7 - Atoms and Molecules 8 - The Periodic Table 9 - Formulae and Calculations 10 - Formulae and Calculations Part 2 11 - Concentration and Volumes 12 - Ionic Bonding 13 - Covalent Bonding 14 - Metallic Bonding 15 - Electrolysis 16 - Group 1 Elements 17 - Group 7 Elements 18 - Atmospheric Gases 19 - Metals and the Reactivity Series 20 - The Uses of Metals 21 - Acids and Alkalis 22 - Titrations 23 - Acids, Bases and Salts 24 - Making Salts 25 - Chemical Tests 26 - Energetics 27 - Bond Energies 28 - Rates of Reaction 29 - Reversible Reactions 30 - Dynamic Equilibria 31 - Organic Compounds 32 - Crude Oil 33 - Burning Hydrocarbons 34 - Alkanes and Alkenes 35 - Organic Compounds Part 2 36 - Esters 37 - Addition Polymers 38 - Condensation Polymers Complete set of companion PDF worksheets for **Edexcel IGCSE Physics** (4PH1) **Chapters 1 - 8**. This pack contains **33** worksheets, including: 1 - Distance and Speed 2 - Acceleration 3 - Forces 4 - Balanced and Unbalanced Forces 5 - Gravity, Weight and Drag 6 - Hooke’s Law 7 - Momentum 8 - Forces and Moments 9 - Mains Electricity 10 - Power, Current and Voltage 11 - Circuits Part 1 12 - Circuits Part 2 13 - Static Electricity 14 - Waves 15 - Electromagnetic Waves 16 - Reflection and Refraction 17 - Sound Waves 18 - Energy 19 - Thermal Energy 20 - Work and Power 21 - Sources of Energy 22 - Density and Pressure 23 - Changes of State 24 - Ideal Gases 25 - Magnetism 26 - Electromagnets Part 1 27 - Electromagnets Part 2 28 - Radioactivity Part 1 29 - Radioactivity Part 2 30 - Fission and Fusion 31 - The Universe 32 - The Evolution of Stars 33 - Cosmology
Something went wrong, please try again later.
This resource hasn't been reviewed yet
To ensure quality for our reviews, only customers who have purchased this resource can review it
Report this resourceto let us know if it violates our terms and conditions.
Our customer service team will review your report and will be in touch.